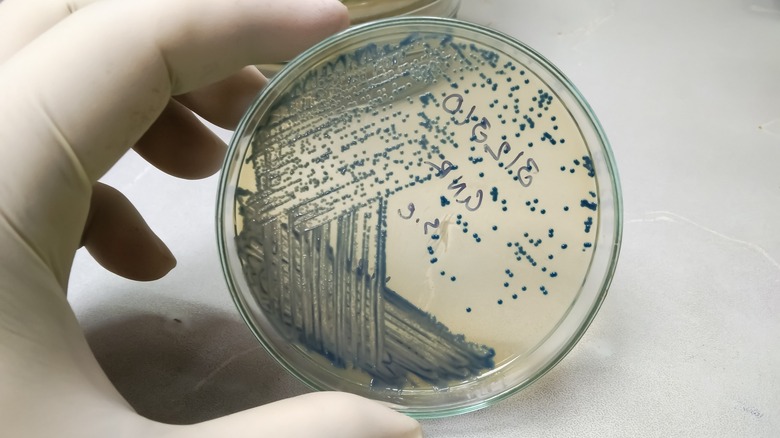

CDC Declares Onions Are Likely The Source Of McDonald's E. Coli Outbreak
McDonald's suspected link to an ongoing outbreak of E. coli now has an official source. On October 30, 2024, the Centers for Disease Control (CDC) declared that the yellow onions served on the chain's Quarter Pounders and some other menu items are likely to blame. The organization came to this conclusion utilizing epidemiological data and traceback information from those affected.
The onions in question were provided by Taylor Farms and have since been recalled. Because Taylor Farms largely services businesses, and not grocery stores (and due to the recall), the CDC has stated that consumers should not be concerned about eating the vegetable.
The CDC first announced its investigation into the outbreak on October 22; at that time, 49 individuals in 10 states had been sickened since September 27, and one had died. On October 23, 2024, McDonald's USA President Joe Erlinger responded to the outbreak on an episode of Today, announcing that the chain took "swift action" to remove the Quarter Pounder from the menu amid concerns that either the onions or the beef patty were the probable cause of the E. coli outbreak.
Since then, the amount of people who have become ill, as reported by the CDC, has risen to 90 (27 of whom have been hospitalized) and cases have spread across 13 states, though the last reported sickness had an onset date of October 16. Meanwhile, McDonald's has returned the Quarter Pounder to its menu, stating confidence that the source of the outbreak had been effectively removed from the menu.
What is E. coli and how to avoid it
Most of the E. coli cases linked to McDonald's have been reported in Colorado, Iowa, Kansas, Michigan, Missouri, Montana, Nebraska, New Mexico, Oregon, Utah, Washington, Wisconsin, and Wyoming. For anyone concerned about the illness, here is what E. coli actually is: It's a type of bacteria, and many strains are actually helpful to humans. But some can cause severe illness. Per Mayo Clinic, symptoms of E. coli can include gastrointestinal issues like diarrhea, nausea, vomiting, cramping as well as hemolytic uremic syndrome and urinary tract infections. In more severe situations, E. coli can cause pneumonia, sepsis, and death.
Avoiding E. coli may be challenging when it's foodborne, but choosing pasteurized dairy products like cheese and milk is one way to minimize the risk. Also, ensuring that you cook meat to the recommended temperature will help prevent sickness. And hand-washing is a must to avoid becoming ill from E. coli, particularly if you have been around others who have been sickened by it.
If you suspect that you have come in contact with E. coli and have symptoms of infection, you should be sure to call your doctor or head to the emergency room for severe cases.